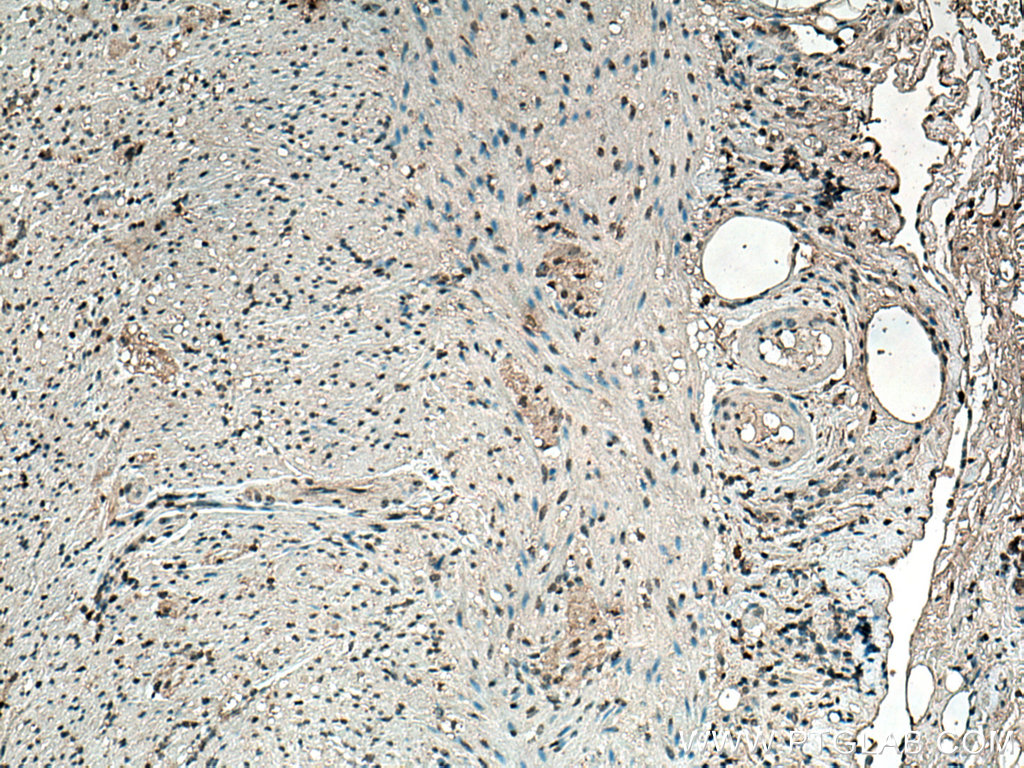

验证数据展示
经过测试的应用
| Positive WB detected in | rabbit brain tissue, rat brain tissue, rat cerebellum tissue, rat spinal cord tissue |
| Positive IHC detected in | rat brain tissue, human appendicitis tissue Note: suggested antigen retrieval with TE buffer pH 9.0; (*) Alternatively, antigen retrieval may be performed with citrate buffer pH 6.0 |
| Positive IF-P detected in | rat brain tissue |
推荐稀释比
| 应用 | 推荐稀释比 |
|---|---|
| Western Blot (WB) | WB : 1:1000-1:2000 |
| Immunohistochemistry (IHC) | IHC : 1:1000-1:8000 |
| Immunofluorescence (IF)-P | IF-P : 1:200-1:800 |
| It is recommended that this reagent should be titrated in each testing system to obtain optimal results. | |
| Sample-dependent, Check data in validation data gallery. | |
产品信息
66616-1-Ig targets S100B in WB, IHC, IF-P, ELISA applications and shows reactivity with human, rat samples.
| 经测试应用 | WB, IHC, IF-P, ELISA Application Description |
| 文献引用应用 | WB, IHC, IF |
| 经测试反应性 | human, rat |
| 文献引用反应性 | human, rat |
| 免疫原 |
CatNo: Ag7440 Product name: Recombinant human S100B protein Source: e coli.-derived, PGEX-4T Tag: GST Domain: 1-92 aa of BC001766 Sequence: MSELEKAMVALIDVFHQYSGREGDKHKLKKSELKELINNELSHFLEEIKEQEVVDKVMETLDNDGDGECDFQEFMAFVAMVTTACHEFFEHE 种属同源性预测 |
| 宿主/亚型 | Mouse / IgG1 |
| 抗体类别 | Monoclonal |
| 产品类型 | Antibody |
| 全称 | S100 calcium binding protein B |
| 别名 | S100 beta, 1G10F4, Protein S100 B, Protein S100-B, S100 calcium-binding protein B |
| 计算分子量 | 11 kDa |
| 观测分子量 | 11 kDa |
| GenBank蛋白编号 | BC001766 |
| 基因名称 | S100 Beta |
| Gene ID (NCBI) | 6285 |
| RRID | AB_2881976 |
| 偶联类型 | Unconjugated |
| 形式 | Liquid |
| 纯化方式 | Protein G purification |
| UNIPROT ID | P04271 |
| 储存缓冲液 | PBS with 0.02% sodium azide and 50% glycerol, pH 7.3. |
| 储存条件 | Store at -20°C. Stable for one year after shipment. Aliquoting is unnecessary for -20oC storage. |
背景介绍
S100B is a member of the S100 family of proteins containing 2 EF-hand calcium-binding motifs and has been implicated in the regulation of cellular activities such as metabolism, motility and proliferation. In the nervous system, S100B is constitutively released by astrocytes into the extracellular space and at nanomolar concentrations, it can promote neurite outgrowth and protect neurons against oxidative stress. Within the central nervous system (CNS), S100B is thought to be a marker for astroglial activation, linking astrocyte dysfunction to schizophrenia. In addition to astrocytes, S100B is released from many cell types, such as, adipocytes, chondrocytes, cardiomyocytes and lymphocytes. Serum S100B represents a new biomarker for mood disorders.
实验方案
| Product Specific Protocols | |
|---|---|
| IF protocol for S100B antibody 66616-1-Ig | Download protocol |
| IHC protocol for S100B antibody 66616-1-Ig | Download protocol |
| WB protocol for S100B antibody 66616-1-Ig | Download protocol |
| Standard Protocols | |
|---|---|
| Click here to view our Standard Protocols |
发表文章
| Species | Application | Title |
|---|---|---|
Acta Neuropathol Commun Repetitive mild TBI causes pTau aggregation in nigra without altering preexisting fibril induced Parkinson’s-like pathology burden | ||
ACS Omega Platelet-Rich Plasma Gel-Loaded Collagen/Chitosan Composite Film Accelerated Rat Sciatic Nerve Injury Repair | ||
Front Neurosci Nogo-C Inhibits Peripheral Nerve Regeneration by Regulating Schwann Cell Apoptosis and Dedifferentiation. | ||
Transl Oncol High throughput proteomic and metabolic profiling identified target correction of metabolic abnormalities as a novel therapeutic approach in head and neck paraganglioma. | ||
Exp Neurol Motor neurons transplantation alleviates neurofibrogenesis during chronic degeneration by reversibly regulating Schwann cells epithelial-mesenchymal transition | ||
Neurochem Res Resistin-Inhibited Neural Stem Cell-Derived Astrocyte Differentiation Contributes to Permeability Destruction of the Blood-Brain Barrier. |